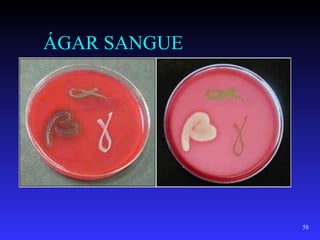
ÁGAR SANGUE




              58
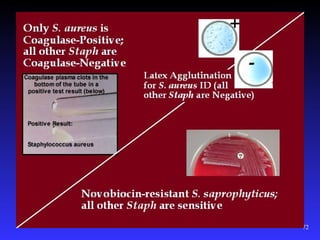
72

O documento descreve as características gerais do Staphylococcus, incluindo sua morfologia, habitat, fatores de virulência e principais manifestações clínicas. O Staphylococcus é um cocogrampositivo facultativo que causa uma variedade de infecções, desde intoxicação alimentar até sepse, e sua patogenicidade é mediada por fatores como a proteína A e as toxinas.